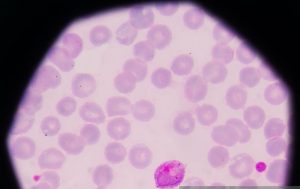

1 Pound in Nepali Rupees Exchange
 Airline crew traveling to Nepal must manage currency exchanges efficiently. The current rate for 1 British pound is approximately 184.56 Nepali rupees, as per the Nepal Rastra Bank. Understanding central bank policies ensures smooth financial transactions during layovers. Timely conversions and adherence to regulations help avoid complications.
Airline crew traveling to Nepal must manage currency exchanges efficiently. The current rate for 1 British pound is approximately 184.56 Nepali rupees, as per the Nepal Rastra Bank. Understanding central bank policies ensures smooth financial transactions during layovers. Timely conversions and adherence to regulations help avoid complications.
1 Pound in Nepali Rupees Today
As of May 28, 2025, the Nepal Rastra Bank’s official exchange rate for 1 pound in Nepali rupees is 184.56 NPR for buying and 185.38 NPR for selling. These rates are updated daily and are crucial for airline crew to monitor. Staying informed helps in planning expenses and conversions effectively.
Central bank’s exchange rate determination
The Nepal Rastra Bank determines exchange rates based on various economic indicators. Factors such as inflation, foreign reserves, and international market trends influence these rates. The bank’s policies aim to maintain economic stability and control currency fluctuations. Airline crew should be aware of these factors to anticipate rate changes.
Authorised exchange facilities
Currency exchanges should be conducted through authorized institutions licensed by the Nepal Rastra Bank. These include banks and official money changers who adhere to the central bank’s regulations. Utilizing authorized facilities ensures fair rates and secure transactions. Airline crew should avoid unauthorized vendors to prevent potential issues.
Documentation requirements
When exchanging currency, proper documentation is essential. Authorized institutions require identification, such as a passport, to process transactions. Receipts should be retained as proof of exchange, which may be necessary for future reference. Maintaining records helps in tracking expenses and complying with regulations.
Transaction limits and regulations
The Nepal Rastra Bank imposes limits on foreign currency exchanges to control capital flow. These limits vary depending on the purpose of the exchange and the traveler’s status. Airline crew should be informed about these limits to plan their conversions accordingly. Exceeding limits without proper authorization can lead to penalties.
Timing of currency exchanges
Exchange rates can fluctuate throughout the day due to market dynamics. Airline crew should monitor rates and choose optimal times for conversions. Early morning rates may differ from those later in the day. Planning exchanges during favorable rate periods maximizes value.
Use of digital tools
Digital platforms and mobile applications provide real-time exchange rate information. Tools like XE and Wise offer up-to-date data, assisting airline crew in making informed decisions. Utilizing these tools enhances convenience and accuracy in currency management.
Security measures
Ensuring the security of currency exchanges is paramount. Transactions should be conducted in safe environments, preferably within bank premises. Avoiding street vendors and unverified sources minimizes risks. Airline crew should prioritize safety during financial transactions.
Handling leftover currency
Upon departure, airline crew may have leftover Nepali rupees. Converting excess currency back to pounds should be done through authorized channels. Retaining receipts from initial exchanges facilitates this process. Proper handling of leftover currency ensures compliance with regulations.
Monitoring economic indicators
Staying informed about Nepal’s economic indicators helps anticipate currency trends. Factors like inflation rates, foreign investment, and trade balances influence exchange rates. Airline crew can adjust their currency strategies based on these indicators. Proactive monitoring aids in financial planning during travels.
Utilising prepaid travel cards
Prepaid travel cards offer a secure alternative to carrying cash. These cards can be loaded with pounds and used for transactions in Nepal. They often provide competitive exchange rates and reduce the need for physical currency. Airline crew benefit from the convenience and security of prepaid cards.
Service charges
Currency exchanges may involve service charges or fees. Authorized institutions disclose these charges upfront. Airline crew should inquire about any additional costs associated with currency conversions. Being aware of fees helps in budgeting and expense management.
Exchange rate forecasting
Analyzing historical exchange rate data assists in forecasting future trends. Airline crew can use this information to plan conversions during favorable periods. While predictions are not guaranteed, informed decisions can lead to better outcomes. Utilizing forecasting tools enhances currency management strategies.
Coordination with airline management
Airline companies often provide guidelines for currency exchanges during international assignments. Crew members should coordinate with management for recommended practices. Following company protocols ensures compliance and facilitates smooth financial operations. Effective communication with management supports successful currency handling.
Efficient currency management strategies
Implementing efficient currency management strategies enhances the travel experience for airline crew. By staying informed about exchange rates, utilizing authorized channels, and planning transactions, crew members can navigate financial aspects confidently. Proactive measures contribute to seamless operations during international assignments.